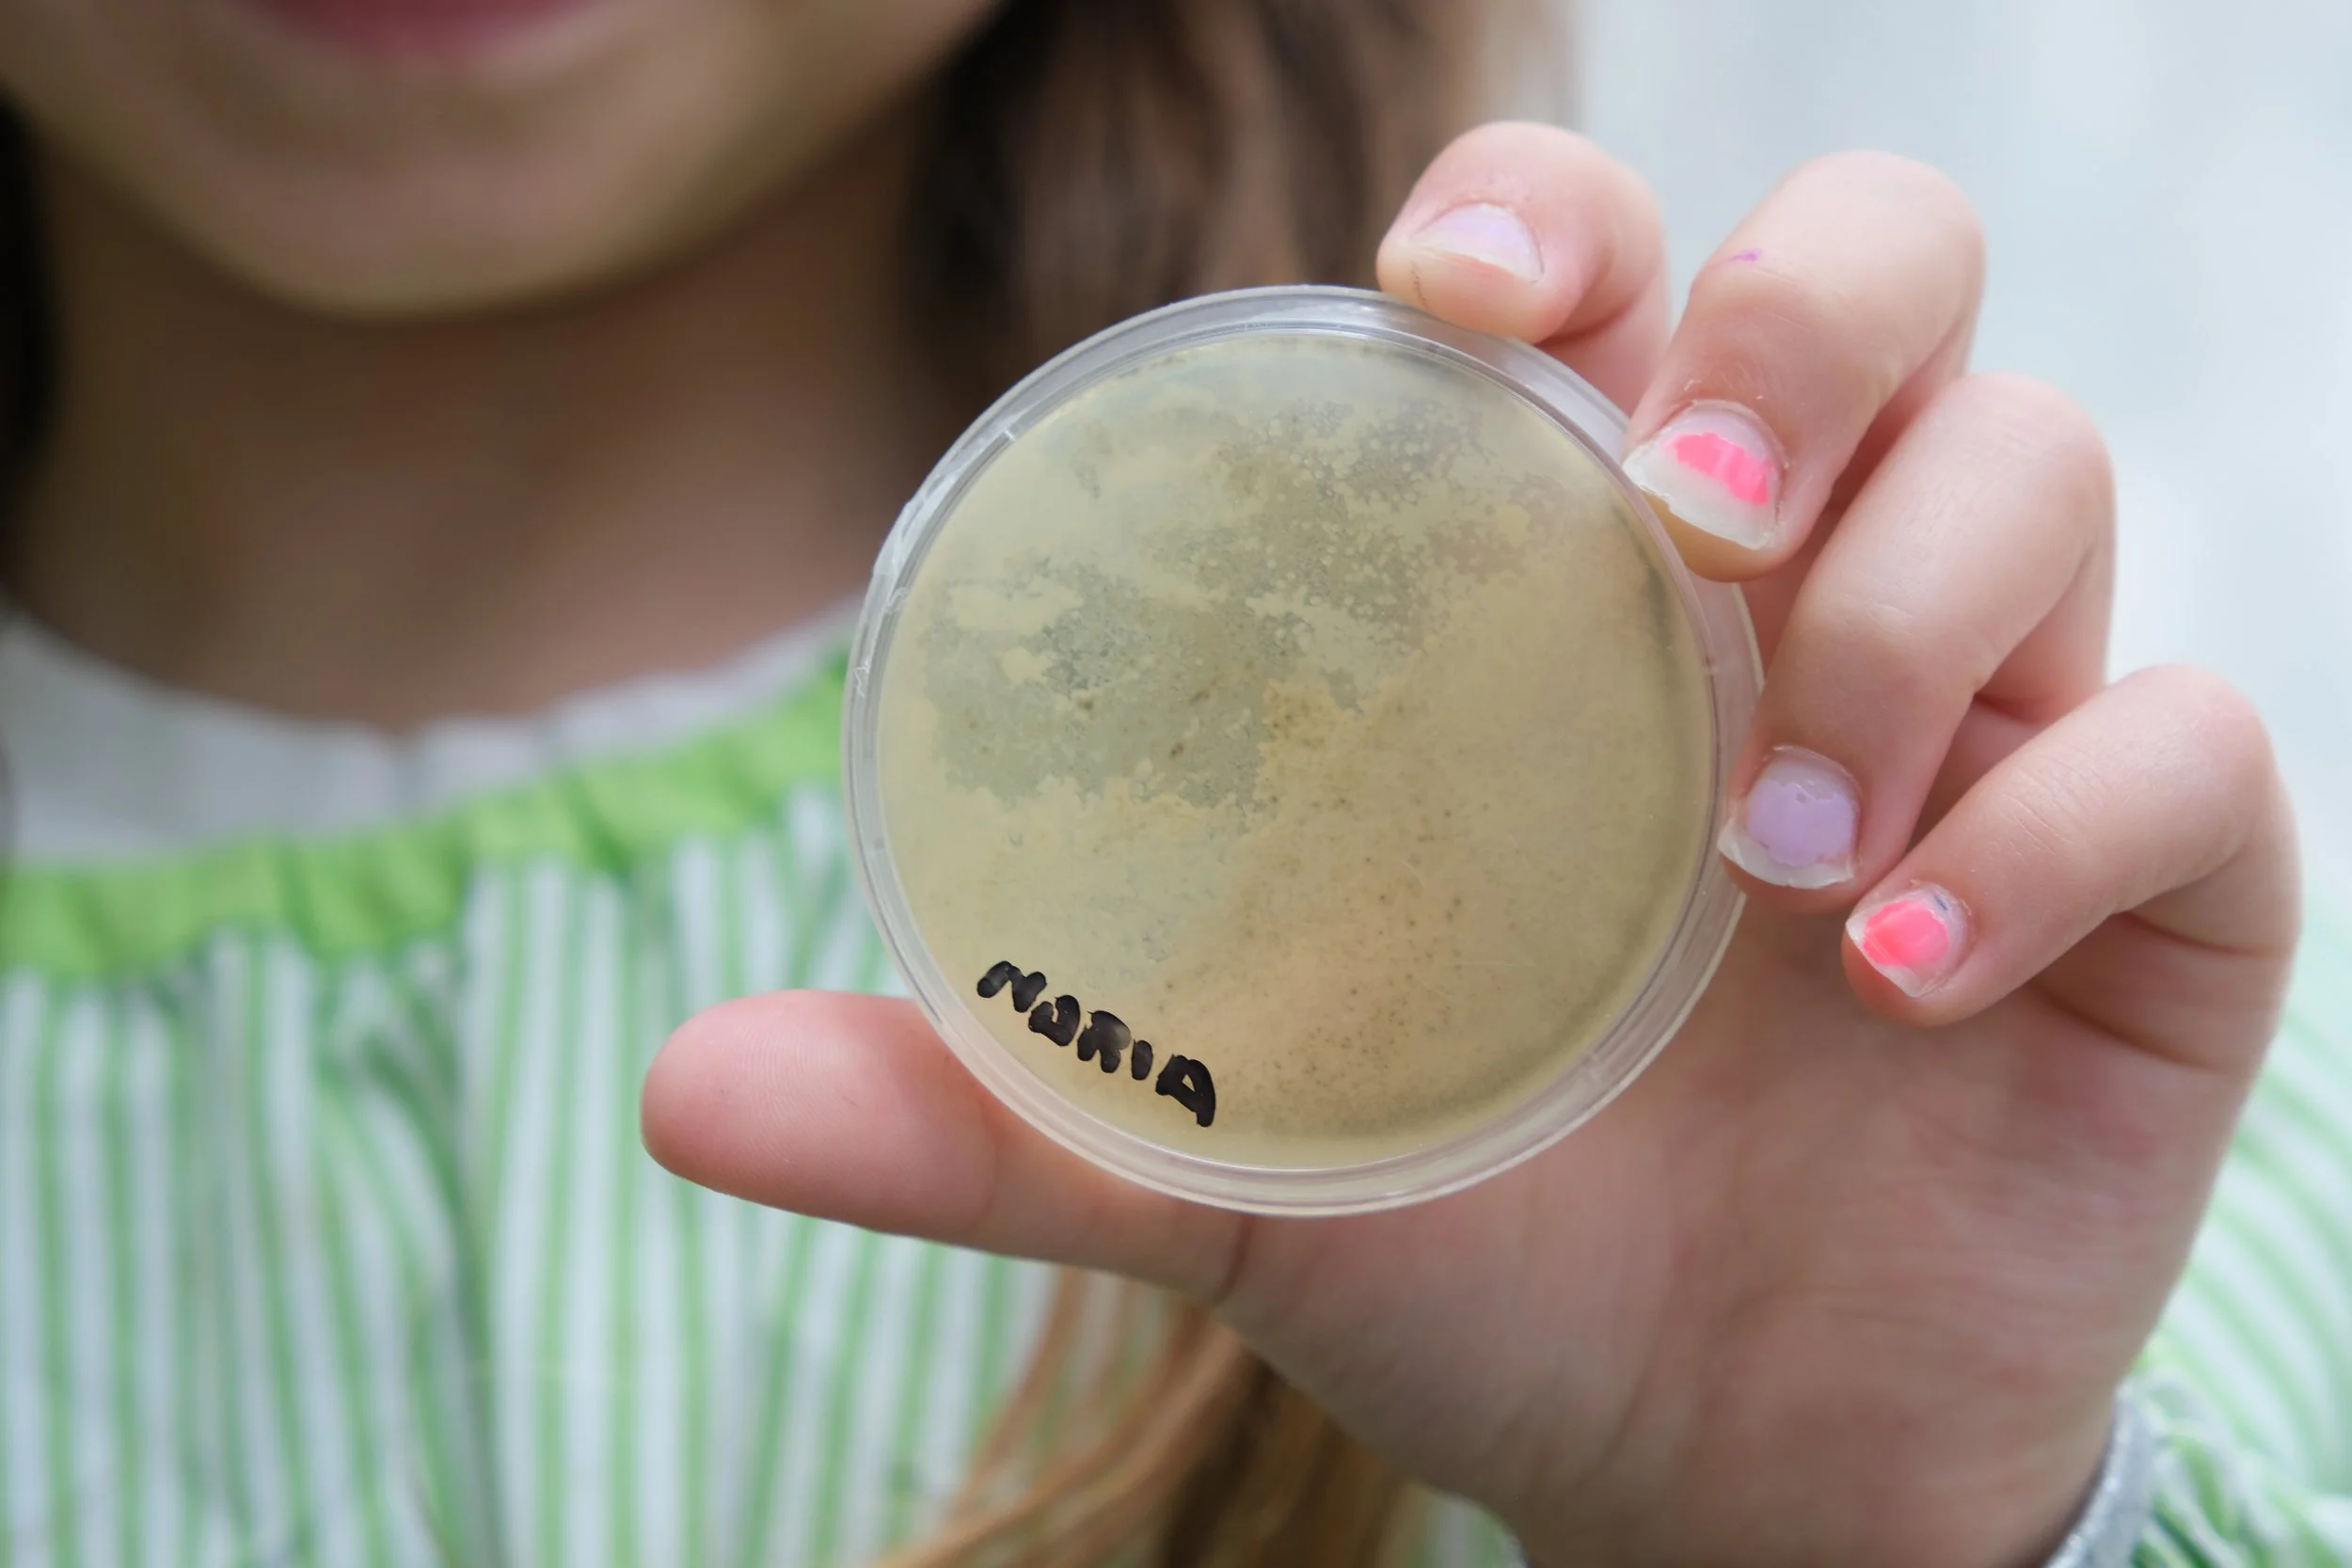
DSCF8518.JPG
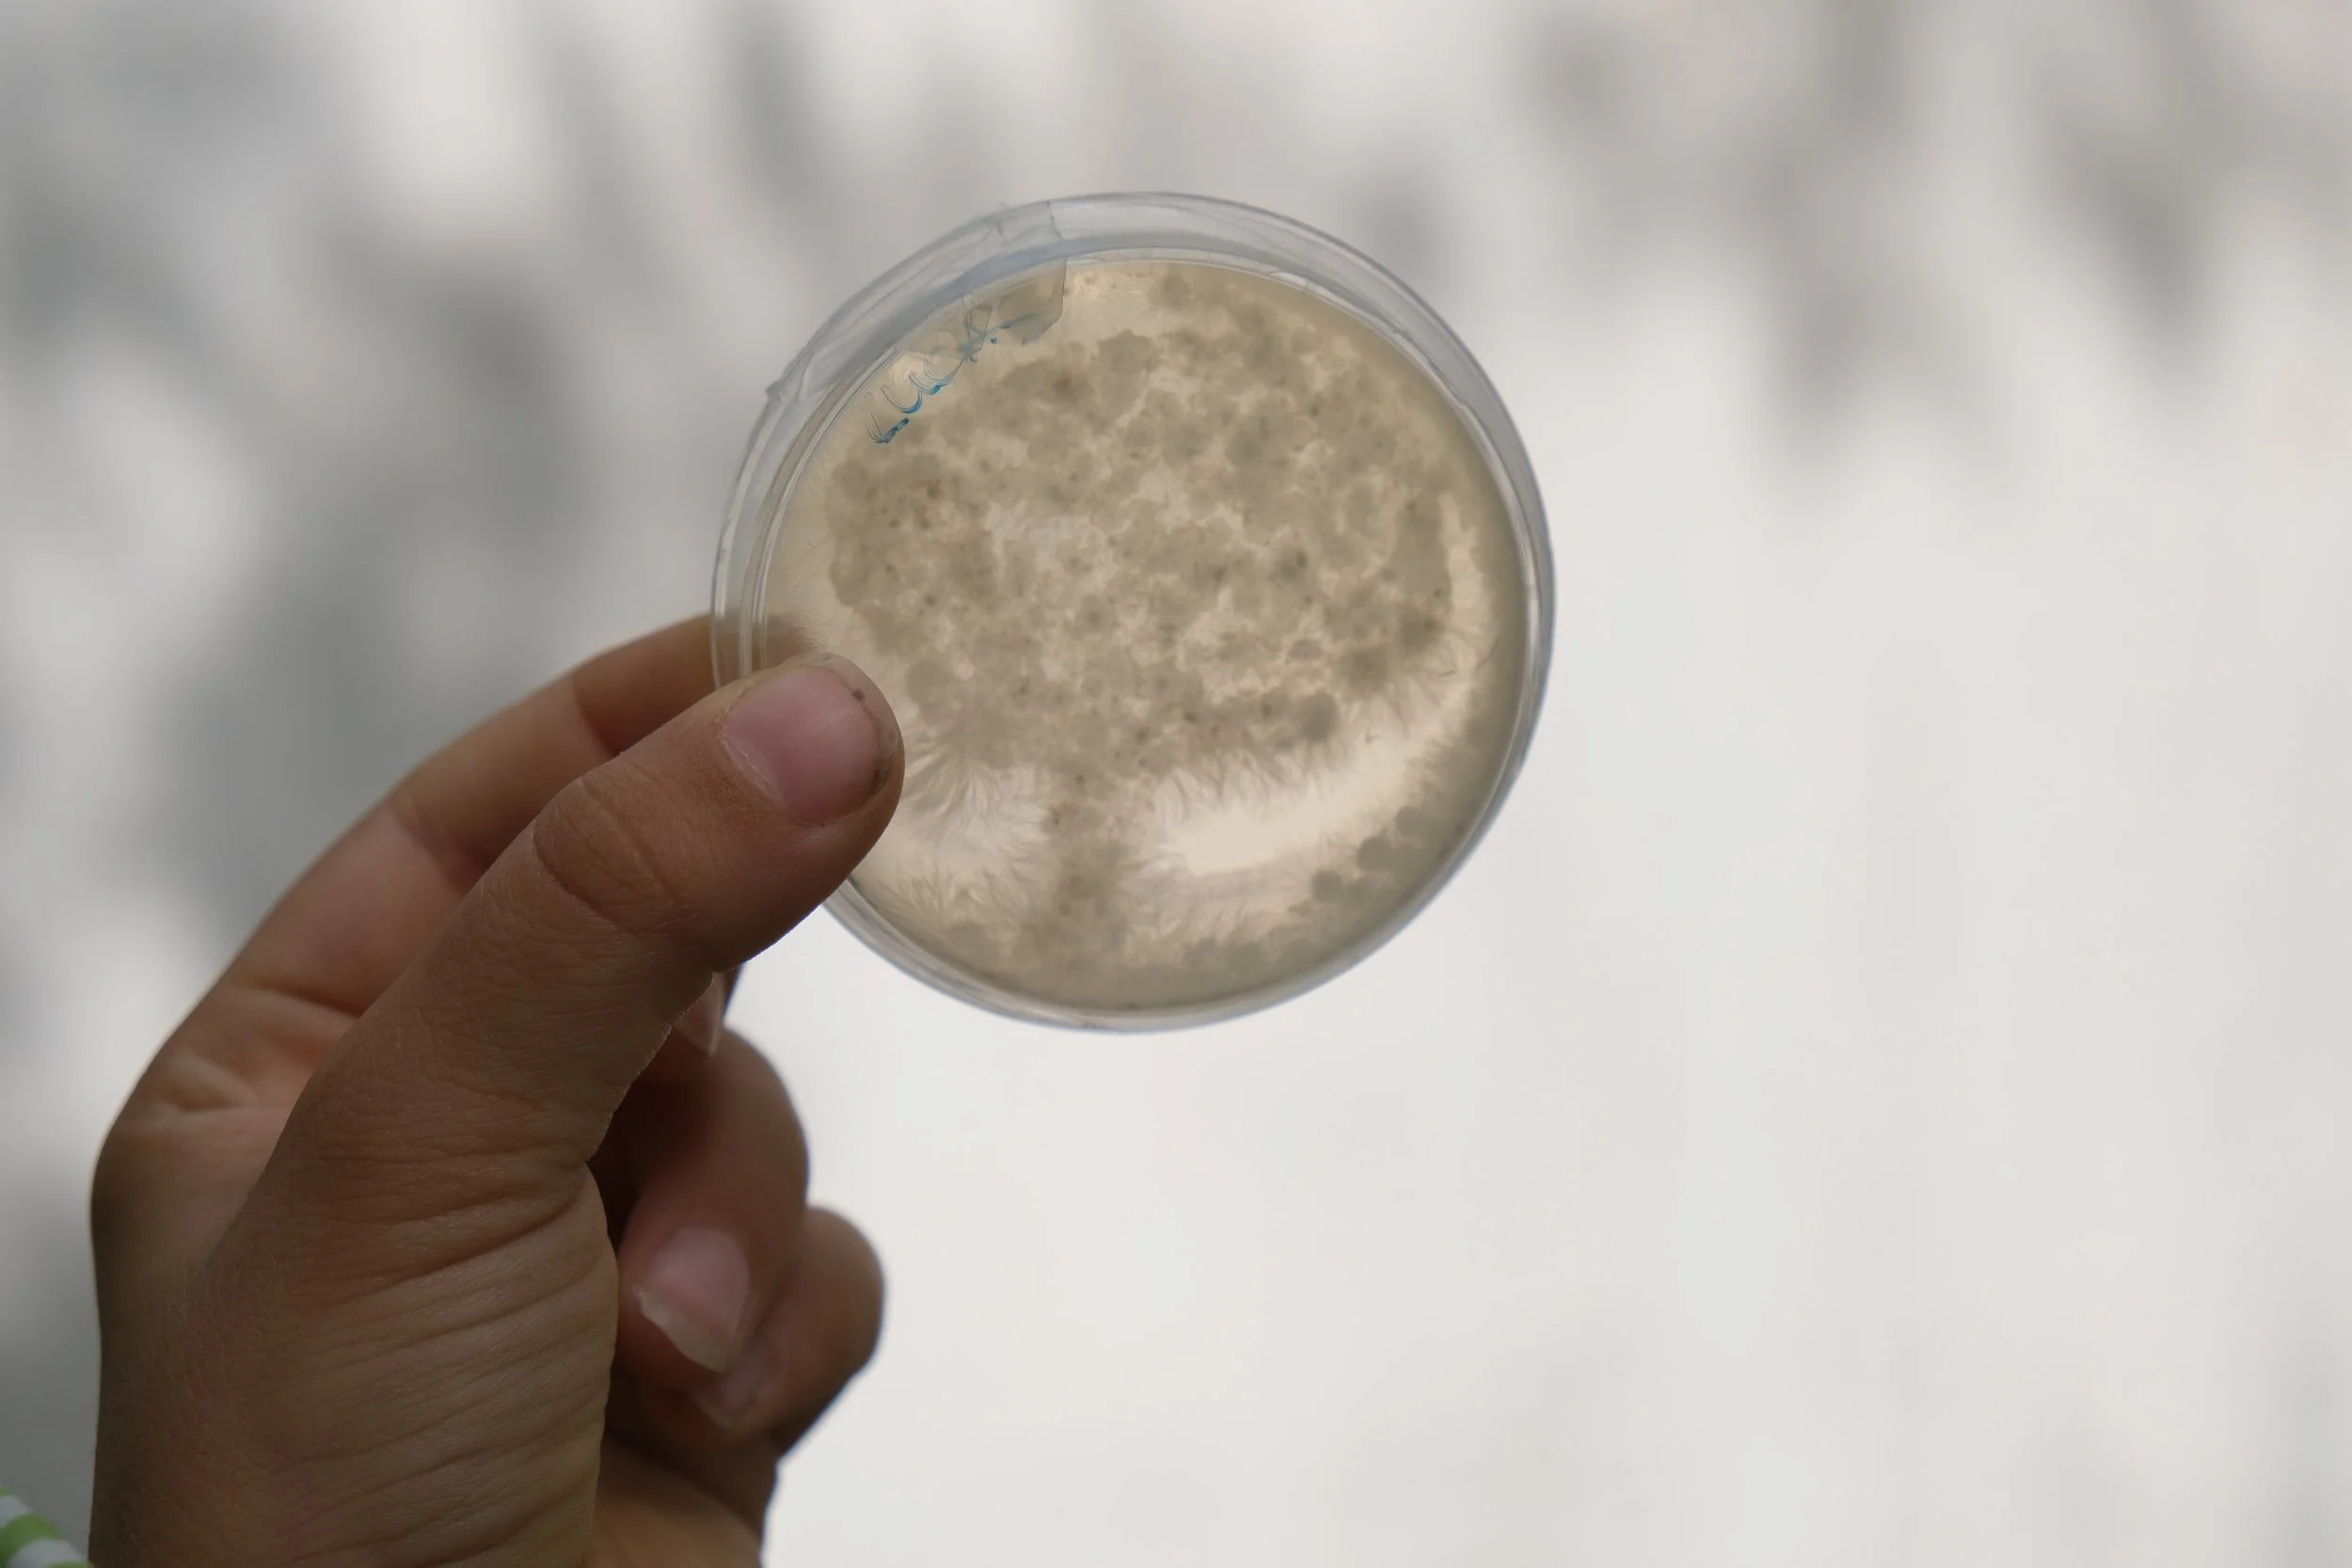
DSCF8577.JPG
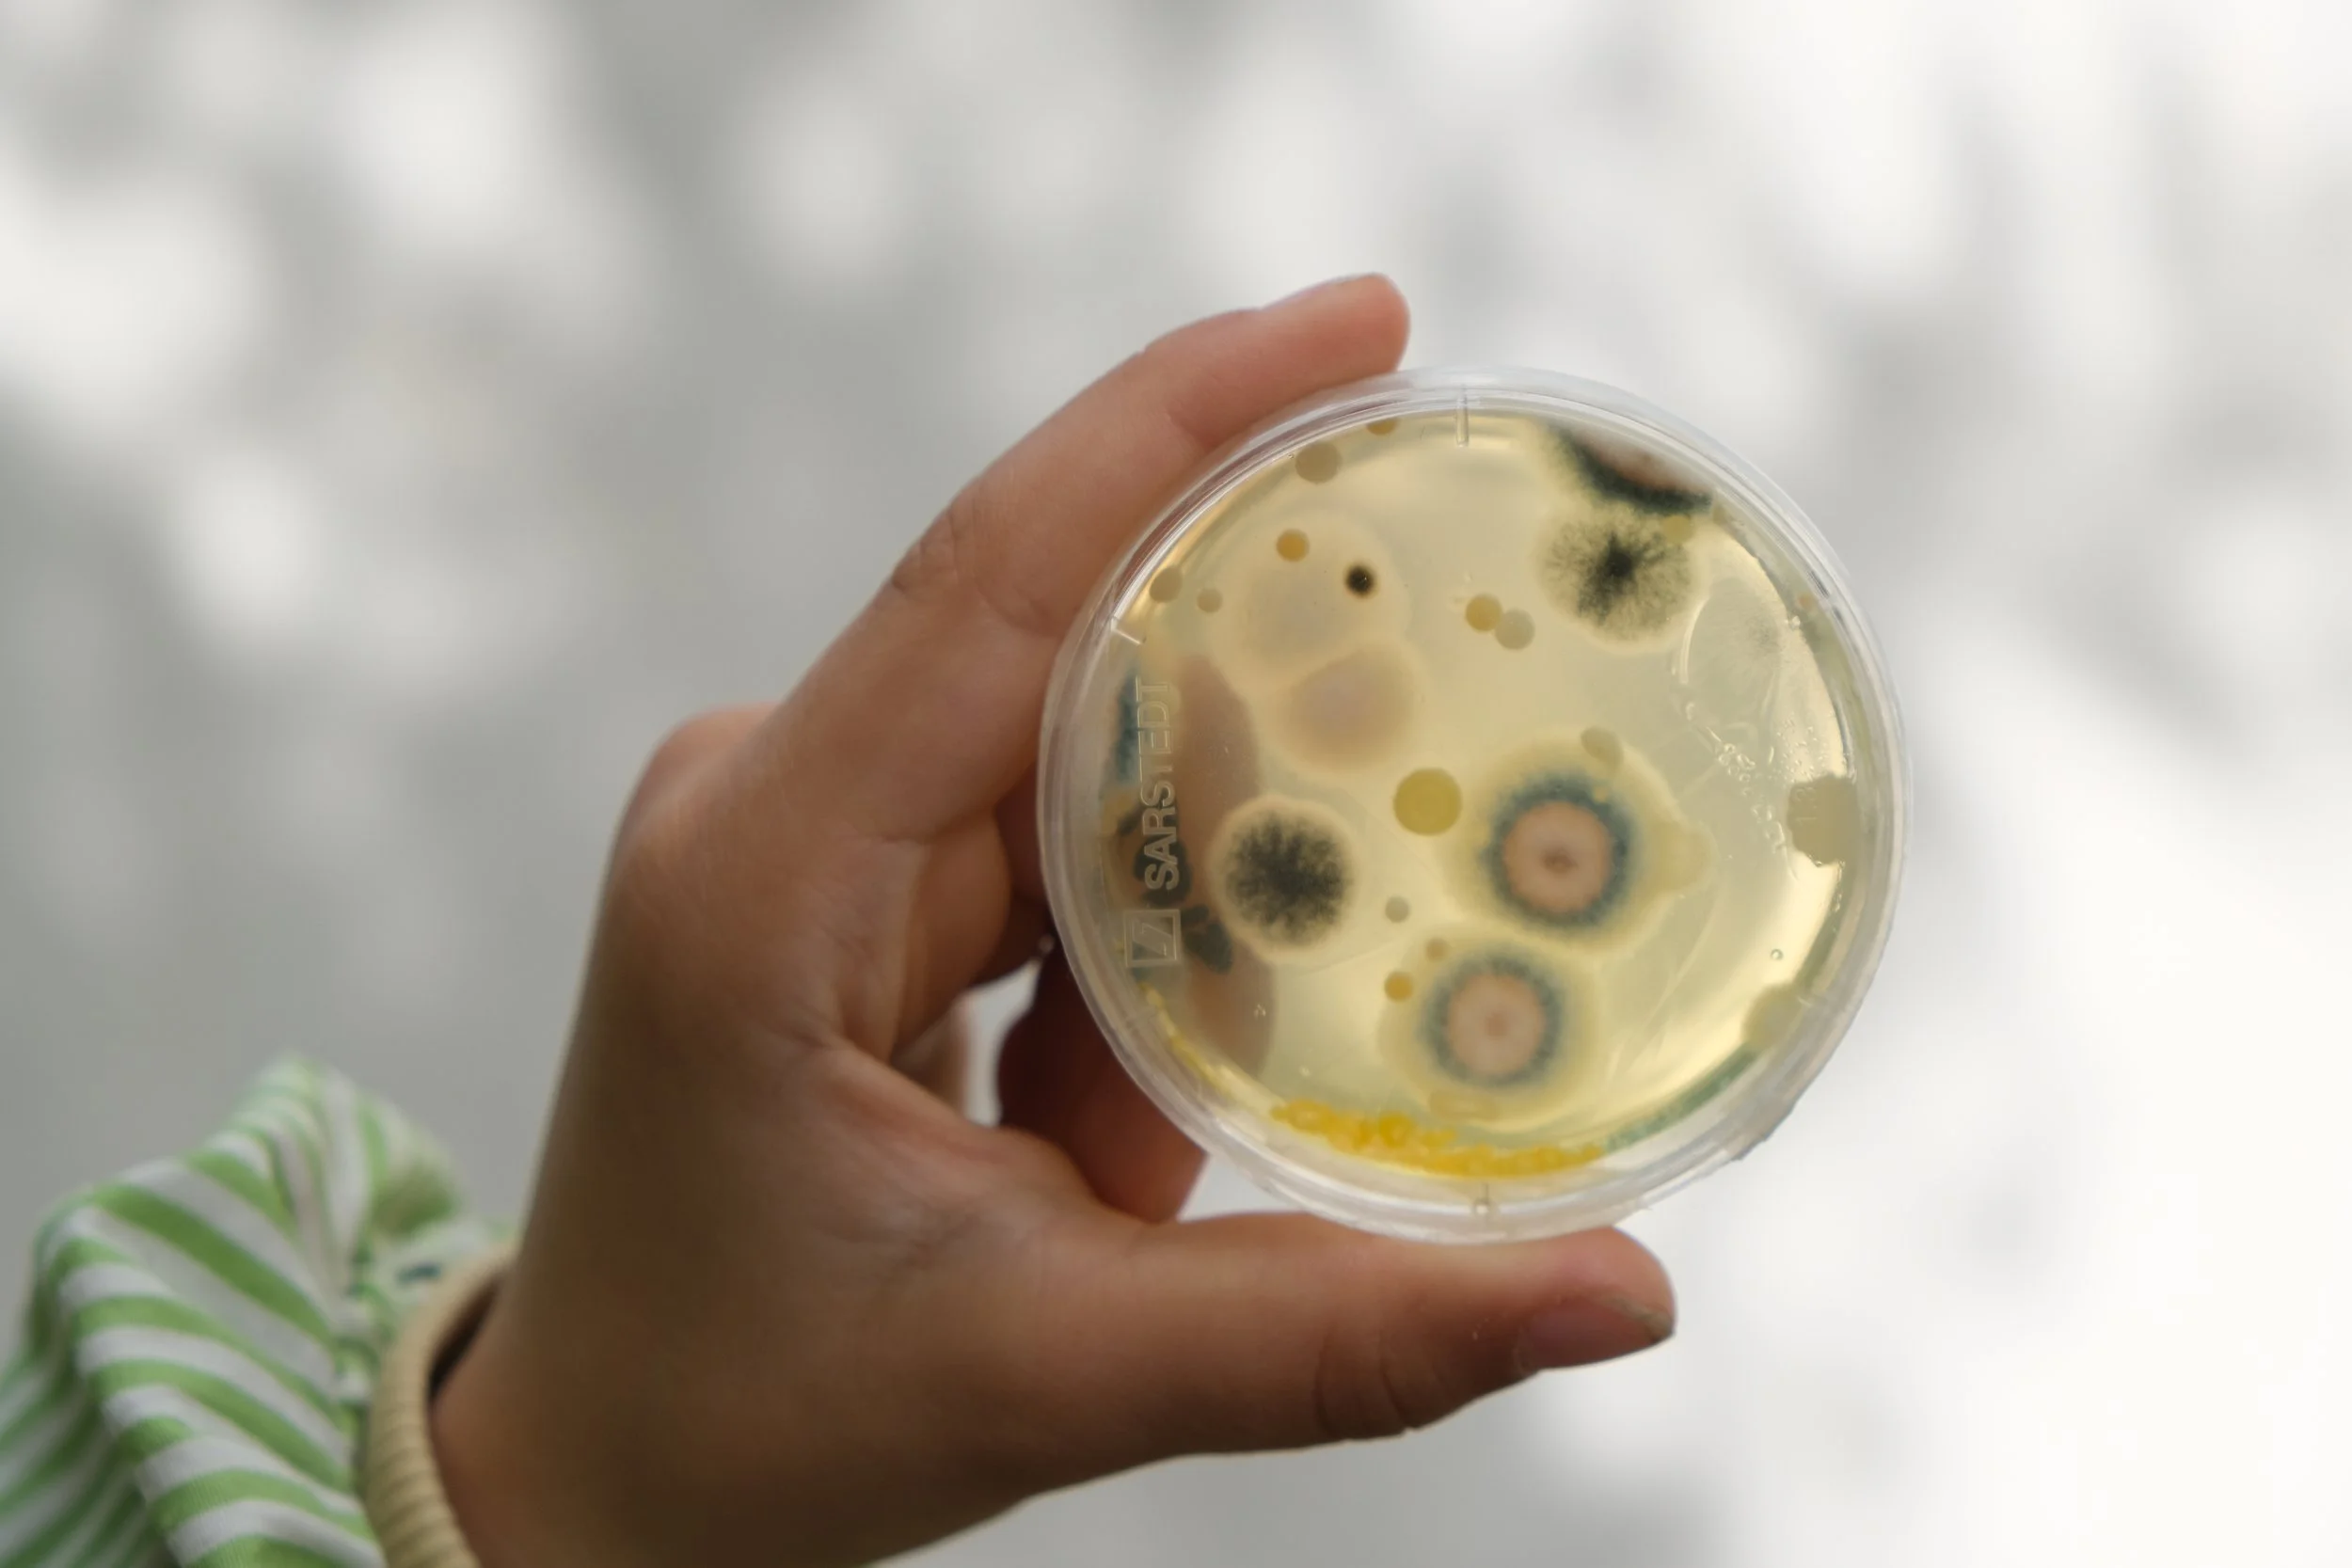
DSCF8621.JPG
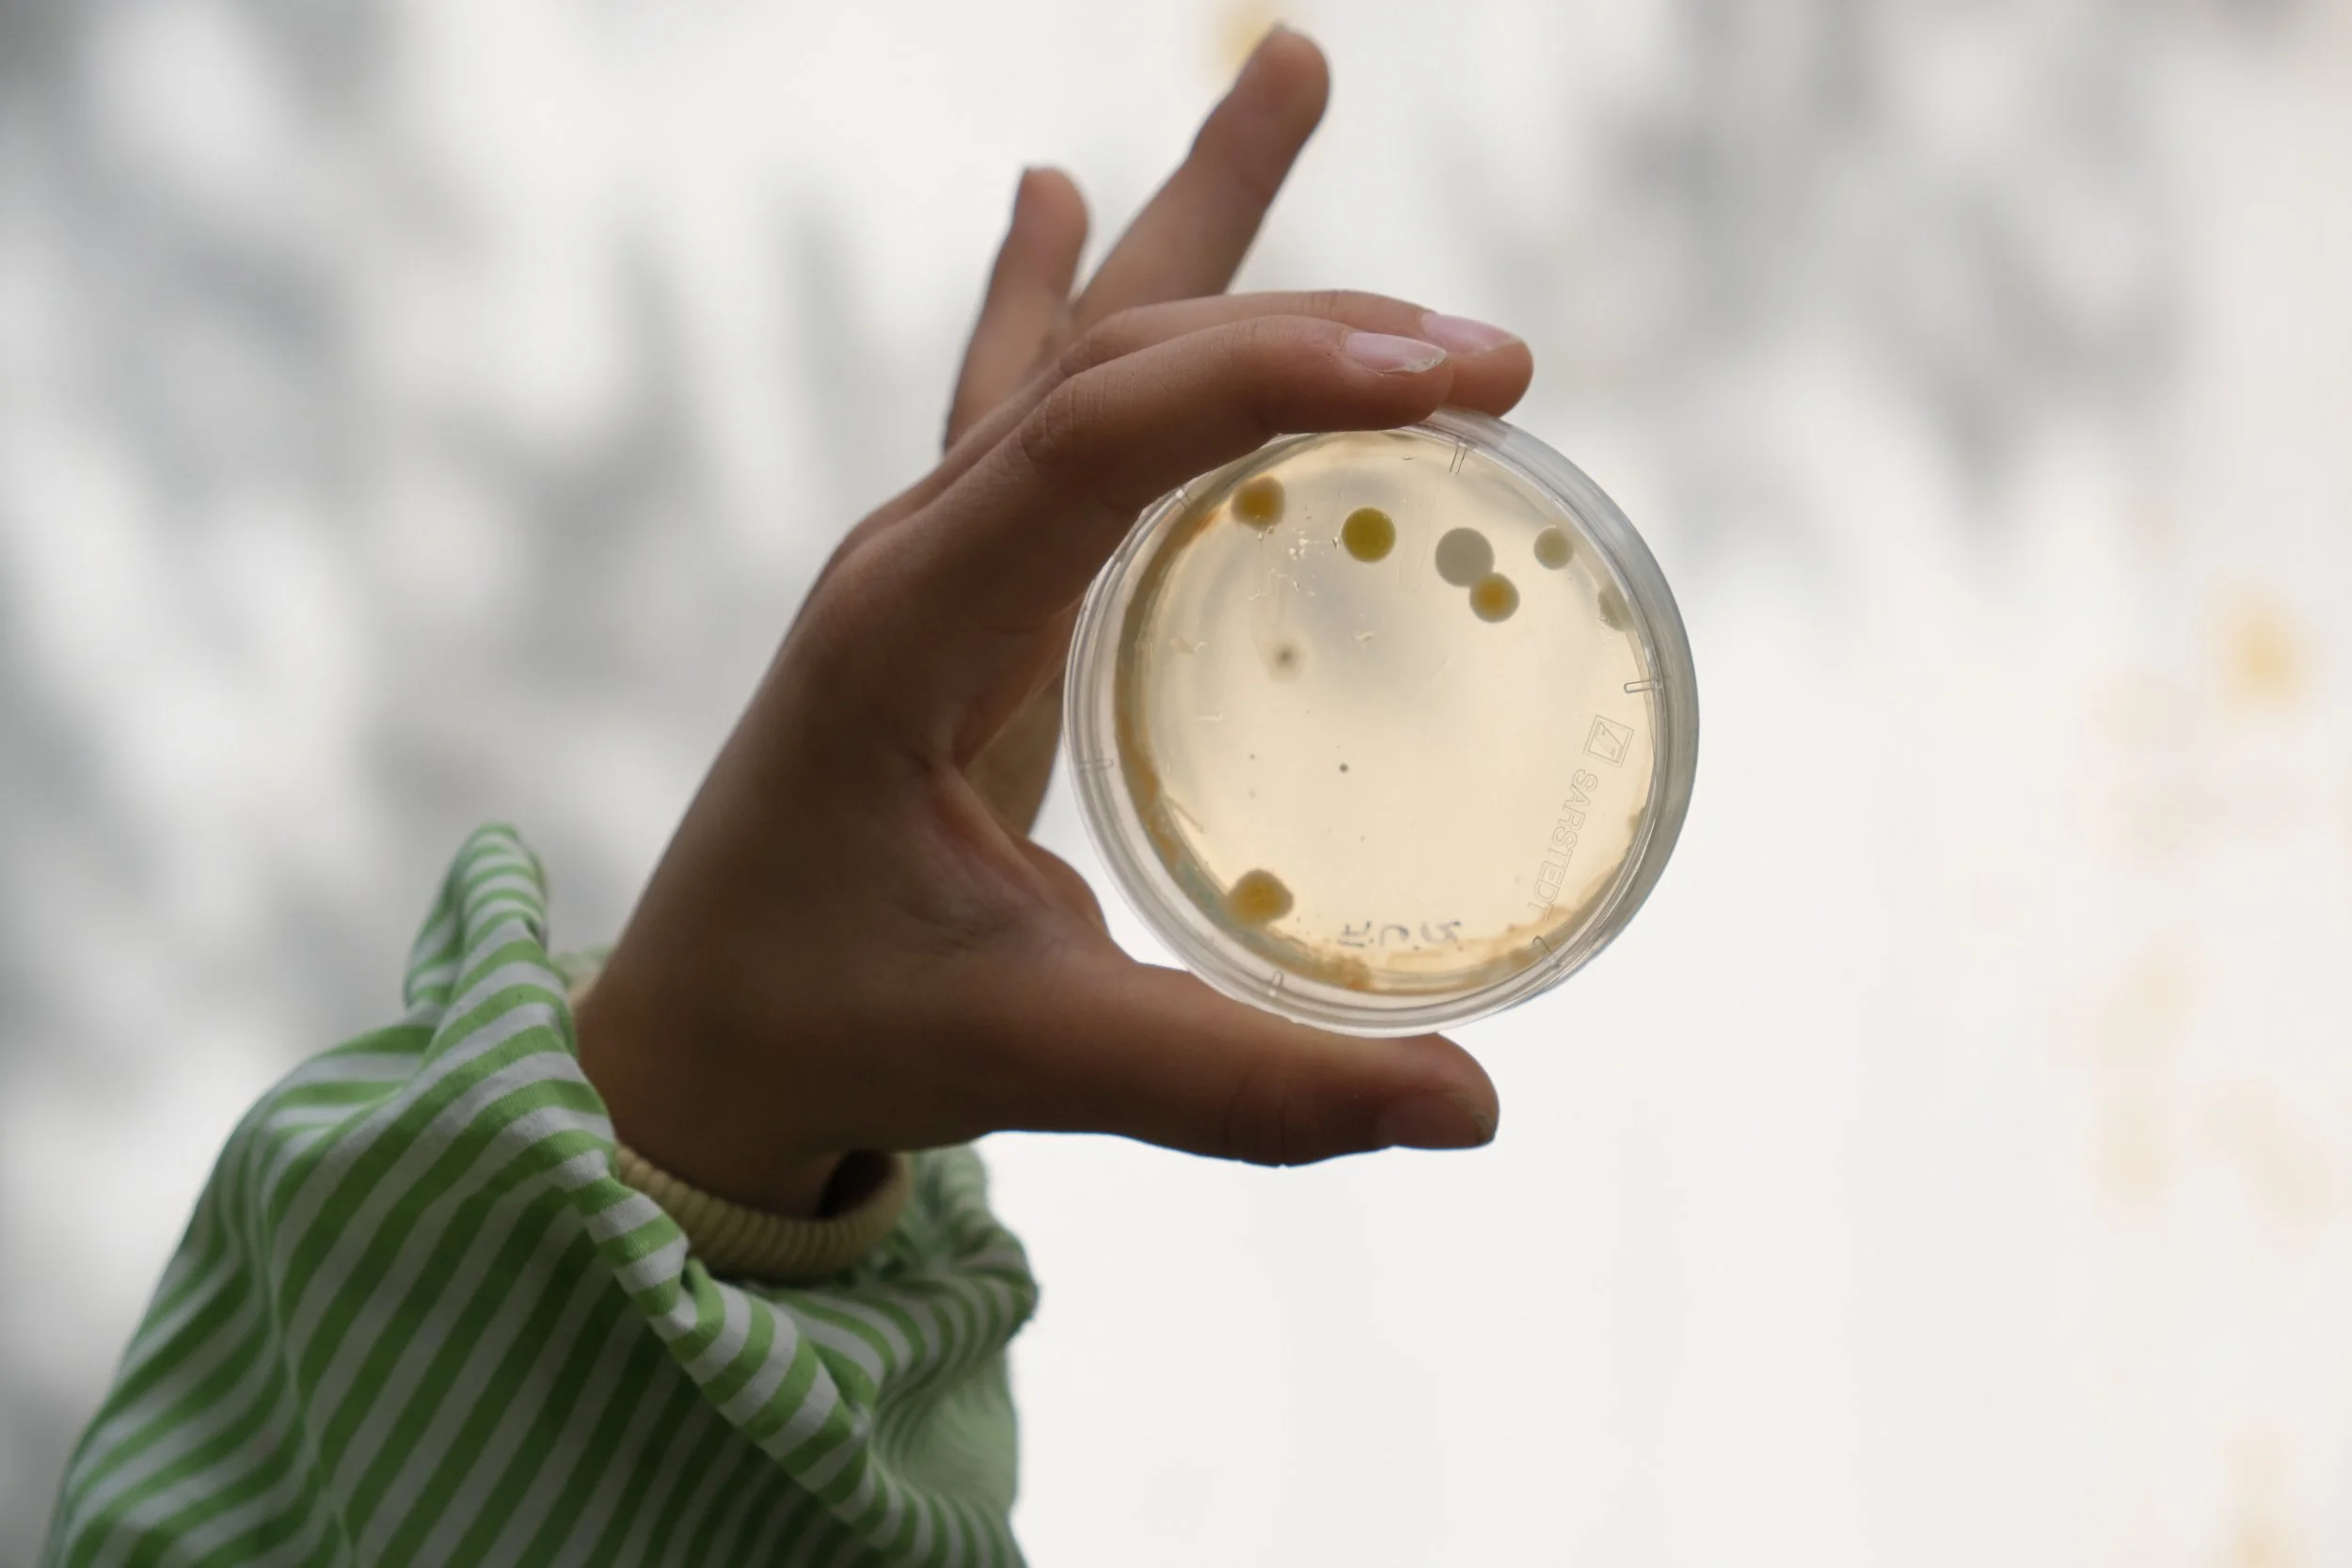
DSCF8631.JPG
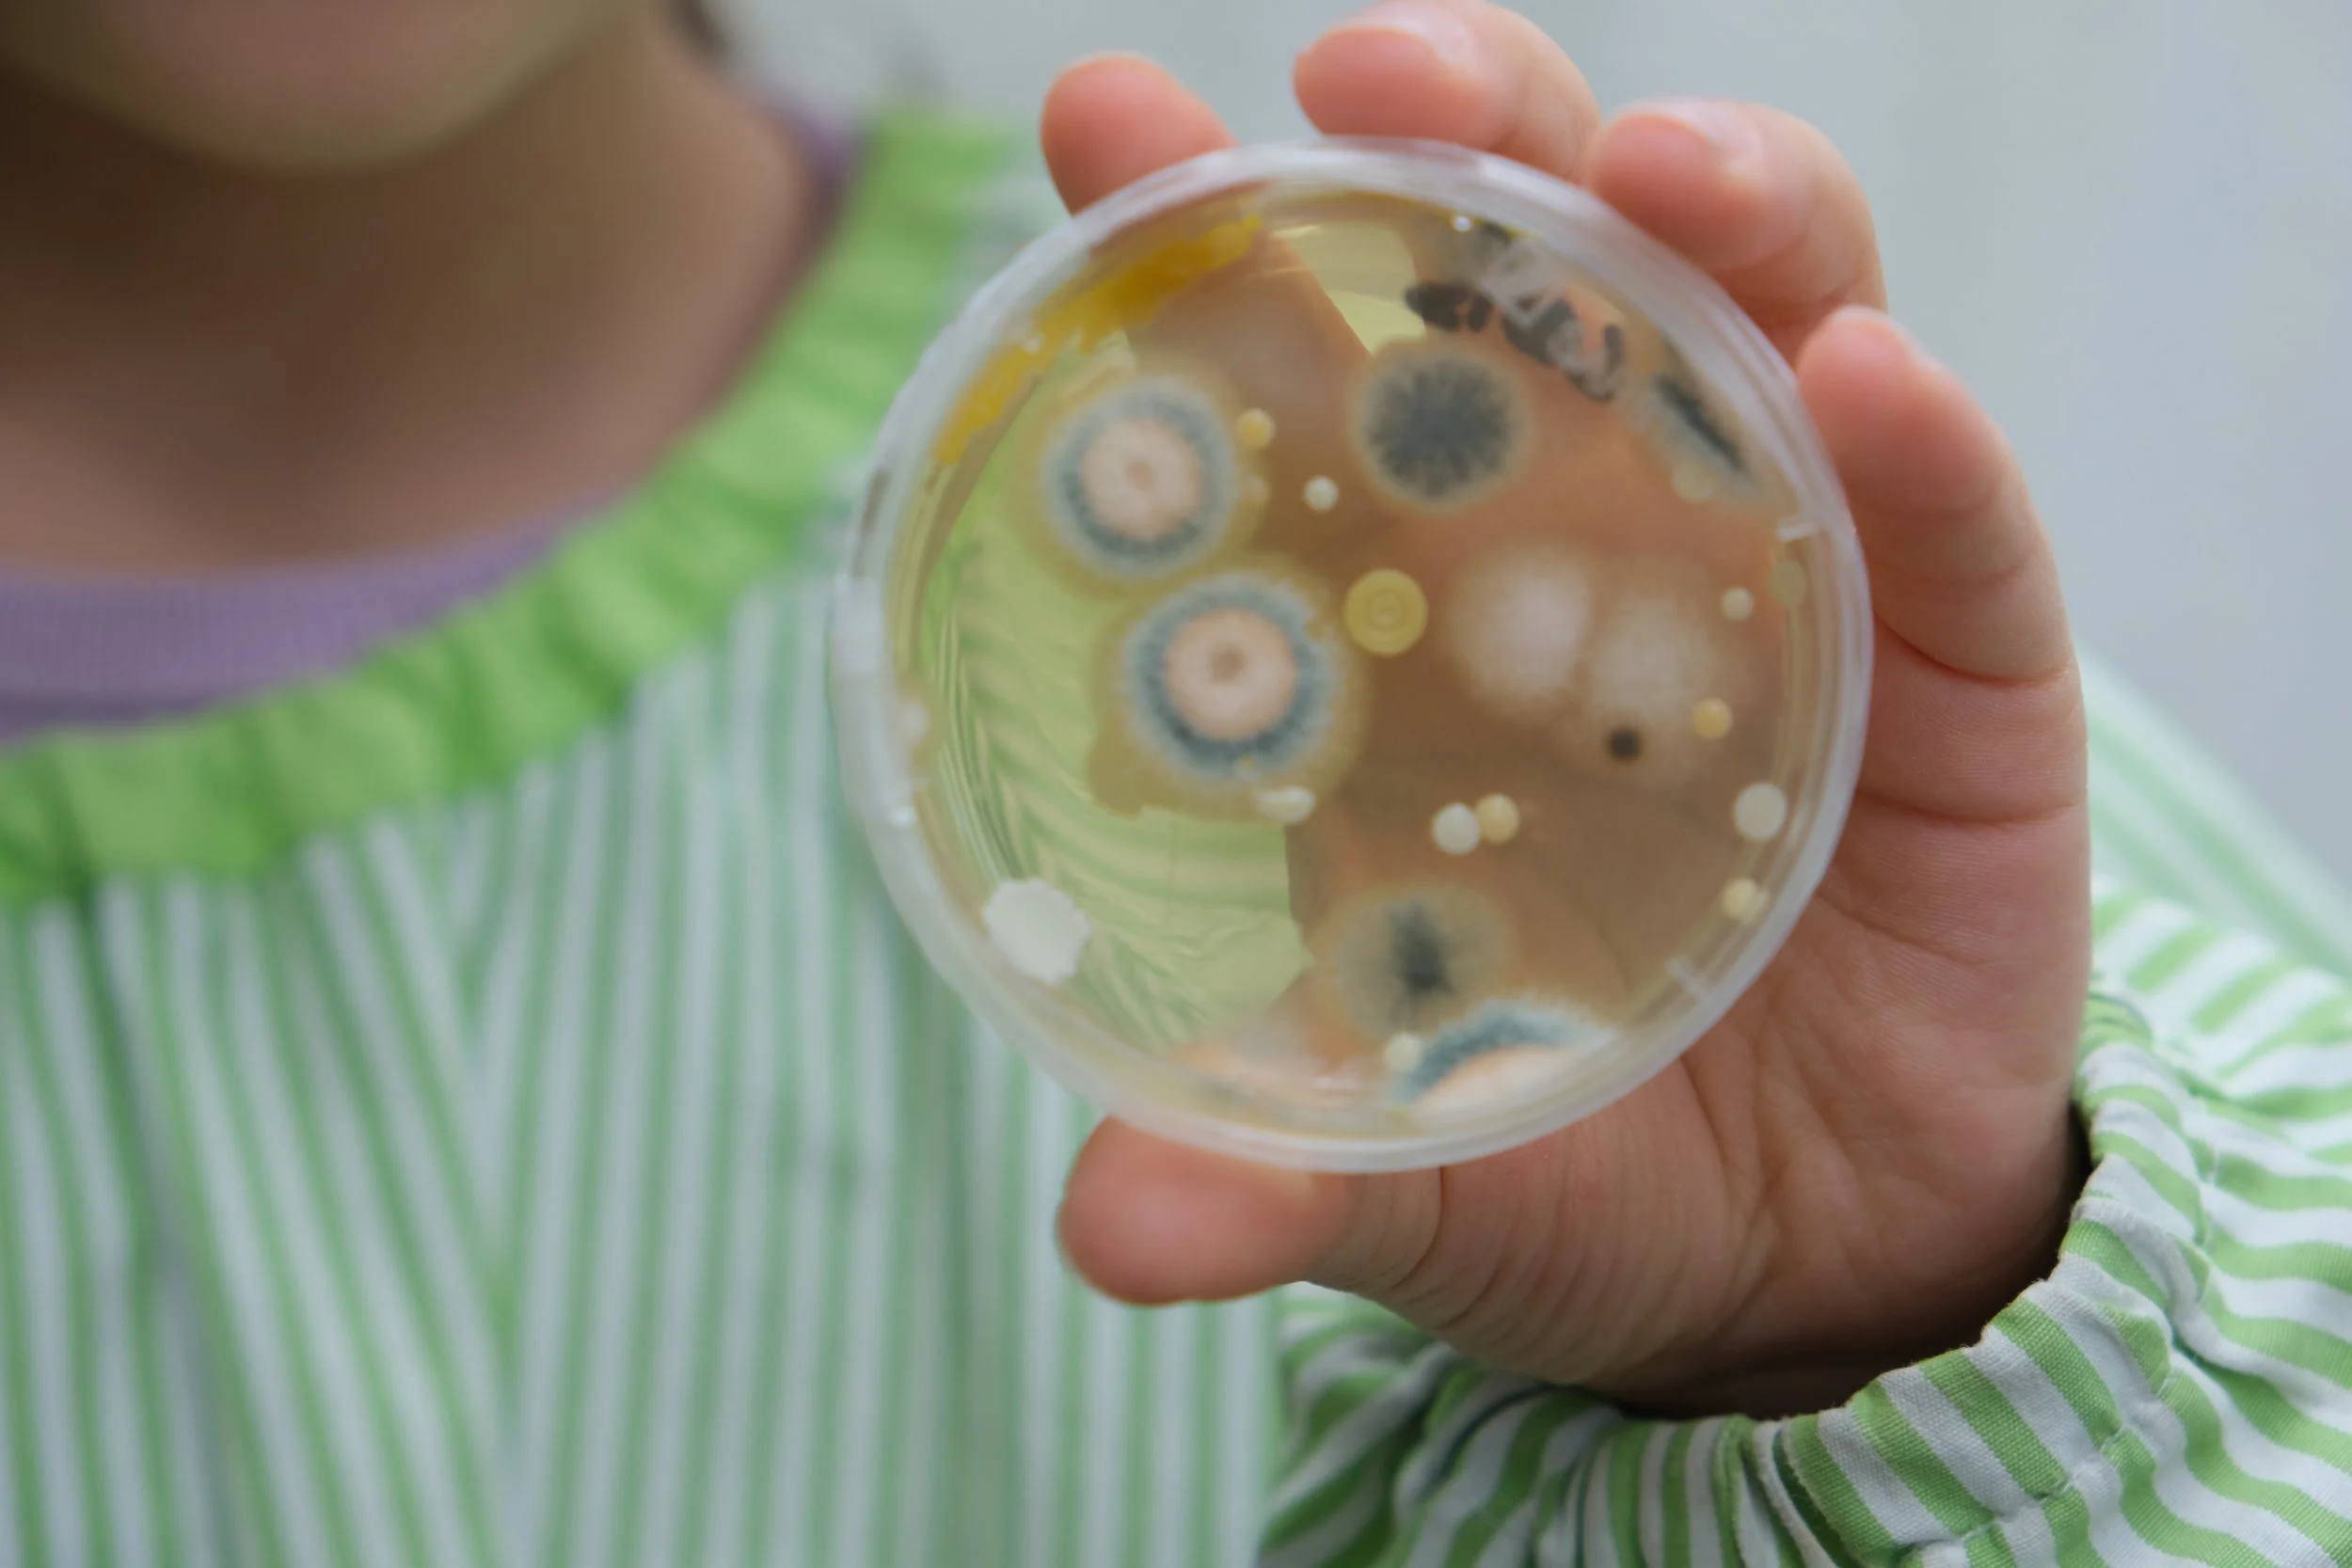
DSCF8650.JPG

O projeto microMacroMundo desenvolveu-se a partir de uma parceria entre a OSMOPE, o i3S e a FBAUP, explorando a relação da Escola com a investigação Científica, mediada pelo Design, envolvendo profissionais de diversas áreas - científicas, artísticas e pedagógicas - e atuando diretamente em cerca de 200 crianças dos 3 aos 10 anos de idade. Teve como premissa imediata a deslocação das experiências laboratoriais inerentes ao contexto científico, um ambiente que é, por definição, isolado e de certa forma estanque do mundo quotidiano, para o ambiente escola. Através de workshops transdisciplinares e co-criativos dinamizados por cientistas, designers e ilustradores, as crianças exploraram e imergiram nos conceitos propostos. Devido ao objeto de estudo dos cientistas ser, a maior parte das vezes, apenas visível através de microscópios, as crianças foram orientadas a pensar sobre o invisível, o abstrato, mas com implicações fortes e concretas nas suas vidas. Após o contacto laboratorial com o objeto de estudo, e através de estratégias sensoriais que transportassem o invisível para o visível, as crianças foram provocadas a dar sentido e forma ao novo mundo que haviam visitado. Houve um corte epistemológico com a vida comum, uma experiência imersiva em algo que não faz parte do seu quotidiano, e uma materialização - mais realista ou mais poética - de uma aparente imaterialidade. A percepção da implicação do micro no macro, de como o individual pode condicionar e construir o todo, constituiu o mote para o desenrolar do projeto, e das descobertas que daí nasceram.

Numa primeira fase, os investigadores do i3S visitaram a OSMOPE e falaram sobre alguns conceitos base como: O que é a Ciência? O que faz um cientista? O que é o i3S? O que são microrganismos?
Após esta provocação inicial, foi lançado o primeiro desafio: recolher num Falcon (frasco plástico que levam para casa) uma amostra de algo no qual gostariam de investigar se há ou não a presença de microorganismos. Será que vivem microorganismos na água do lago? E no pêlo do cão? E na banca lá de casa? Numa pedra? Na relva? No cabelo? Deixámos as crianças descobrir onde gostariam de pesquisar a presença de microrganismos.

Numa segunda fase, os investigadores voltaram à escola para ajudar as crianças a descobrir se as amostram continham microrganismos visíveis.
Estas descobertas foram, então, exploradas pela equipa pedagógica, artística e de design, e articuladas com ilustradores mediados pela FBAUP - o Nicolau e a Mariana Malhão -, que trabalharam também com as crianças sobre estes conceitos de micro/macro, visível/invisível, impacto/consequência, numa constante promoção da comunicação da ciência a crianças através do design e da ilustração.




























Este projeto culminou numa exposição imersiva e interativa nas instalações do i3S, onde crianças e adultos puderam explorar os temas e as produções construídas durante todo o processo.